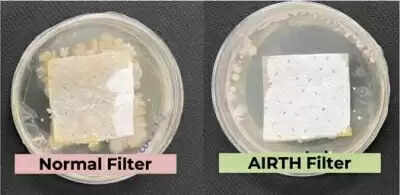

IISc ने कीटाणुओं को नष्ट करने वाले एयर फिल्टर का किया आविष्कार
विज्ञान और इंजीनियरिंग अनुसंधान बोर्ड (एसईआरबी) से विशेष अनुदान द्वारा समर्थित एक नव-विकसित एयर फिल्टर कीटाणुओं को निष्क्रिय कर सकता है। आमतौर पर ग्रीन टी में पाए जाने वाले तत्वों का उपयोग करके उन्हें सिस्टम से 'सेल्फ-क्लीनिंग' कर सकता है।
Dec 17, 2022, 18:17 IST
नई दिल्ली, 17 दिसंबर - विज्ञान और इंजीनियरिंग अनुसंधान बोर्ड (एसईआरबी) से विशेष अनुदान द्वारा समर्थित एक नव-विकसित एयर फिल्टर कीटाणुओं को निष्क्रिय कर सकता है। आमतौर पर ग्रीन टी में पाए जाने वाले तत्वों का उपयोग करके उन्हें सिस्टम से 'सेल्फ-क्लीनिंग' कर सकता है। बैंगलोर के भारतीय विज्ञान संस्थान में सूर्यसारथी बोस और कौशिक चटर्जी के नेतृत्व में एक शोध दल ने कीटाणुओं को नष्ट करने वाला एयर फिल्टर बनाया, जो आमतौर पर ग्रीन टी में पाए जाने वाले पॉलीफेनोल्स और पॉलीकेशनिक पॉलिमर जैसे तत्वों का उपयोग करके कीटाणुओं को निष्क्रिय कर सकते हैं। ये तत्व साइट-विशिष्ट बंधन के माध्यम से रोगाणुओं को तोड़ते हैं।
शिकागो विश्वविद्यालय की एक रिपोर्ट के अनुसार, प्रदूषित हवा के कारण भारतीयों के जीवन के 5-10 साल कम हो रहे हैं, क्योंकि हवा से होने वाले दूषित पदार्थों से सांस की बीमारियां होती हैं, जो शारीरिक स्वास्थ्य के साथ-साथ मानसिक स्वास्थ्य पर भी प्रतिकूल प्रभाव डालती हैं।
शोध को चुनौतीपूर्ण कोविड-19 महामारी के दौरान एसईआरबी के विशेष अनुदान और एसईआरबी-टेक्नोलॉजी ट्रांसलेशन अवार्डस (एसईआरबी-टीईटीआरए) फंड द्वारा समर्थित किया गया था और इस पर एक पेटेंट दायर किया गया है।
निरंतर उपयोग से, मौजूदा एयर फिल्टर पकड़े गए कीटाणुओं के लिए प्रजनन स्थल बन जाते हैं। इन कीटाणुओं की वृद्धि फिल्टर के छिद्रों को बंद कर देती है, जिससे फिल्टर का जीवन कम हो जाता है।
शनिवार को विज्ञान और प्रौद्योगिकी मंत्रालय ने कहा, ''यह कीटाणु आसपास के लोगों को संक्रमित कर सकता है। टेस्टिंग और कैलिब्रेशन लेबोरिटी के लिए राष्ट्रीय प्रत्यायन बोर्ड में नोवेल एंटी-माइक्रोबियल एयर फिल्टर का परीक्षण किया गया और 99.24 प्रतिशत की दक्षता के साथ सार्स-सीओवी-2 (डेल्टा वेरिएंट) को निष्क्रिय करने के लिए पाया गया। इस तकनीक को एआईआरटीएच को ट्रांसफर किया गया था, जो एक स्टार्टअप है।''
चूंकि यह इनोवेशन एंटीमाइक्रोबियल फिल्टर विकसित करने का वादा करता है, जो प्रदूषित हवा से होने वाले रोगों को रोक सकता है। इसे 2022 में एक पेटेंट प्रदान किया गया था।
मंत्रालय ने कहा, ''हमारे एसी, सेंट्रल डक्ट और एयर प्यूरीफायर में ये नए एंटीमाइक्रोबियल फिल्टर वायु प्रदूषण के खिलाफ हमारी लड़ाई में महत्वपूर्ण भूमिका निभा सकते हैं और कोरोनावायरस जैसे वायु जनित रोगजनकों के प्रसार को कम कर सकते हैं।''
शिकागो विश्वविद्यालय की एक रिपोर्ट के अनुसार, प्रदूषित हवा के कारण भारतीयों के जीवन के 5-10 साल कम हो रहे हैं, क्योंकि हवा से होने वाले दूषित पदार्थों से सांस की बीमारियां होती हैं, जो शारीरिक स्वास्थ्य के साथ-साथ मानसिक स्वास्थ्य पर भी प्रतिकूल प्रभाव डालती हैं।
शोध को चुनौतीपूर्ण कोविड-19 महामारी के दौरान एसईआरबी के विशेष अनुदान और एसईआरबी-टेक्नोलॉजी ट्रांसलेशन अवार्डस (एसईआरबी-टीईटीआरए) फंड द्वारा समर्थित किया गया था और इस पर एक पेटेंट दायर किया गया है।
निरंतर उपयोग से, मौजूदा एयर फिल्टर पकड़े गए कीटाणुओं के लिए प्रजनन स्थल बन जाते हैं। इन कीटाणुओं की वृद्धि फिल्टर के छिद्रों को बंद कर देती है, जिससे फिल्टर का जीवन कम हो जाता है।
शनिवार को विज्ञान और प्रौद्योगिकी मंत्रालय ने कहा, ''यह कीटाणु आसपास के लोगों को संक्रमित कर सकता है। टेस्टिंग और कैलिब्रेशन लेबोरिटी के लिए राष्ट्रीय प्रत्यायन बोर्ड में नोवेल एंटी-माइक्रोबियल एयर फिल्टर का परीक्षण किया गया और 99.24 प्रतिशत की दक्षता के साथ सार्स-सीओवी-2 (डेल्टा वेरिएंट) को निष्क्रिय करने के लिए पाया गया। इस तकनीक को एआईआरटीएच को ट्रांसफर किया गया था, जो एक स्टार्टअप है।''
चूंकि यह इनोवेशन एंटीमाइक्रोबियल फिल्टर विकसित करने का वादा करता है, जो प्रदूषित हवा से होने वाले रोगों को रोक सकता है। इसे 2022 में एक पेटेंट प्रदान किया गया था।
मंत्रालय ने कहा, ''हमारे एसी, सेंट्रल डक्ट और एयर प्यूरीफायर में ये नए एंटीमाइक्रोबियल फिल्टर वायु प्रदूषण के खिलाफ हमारी लड़ाई में महत्वपूर्ण भूमिका निभा सकते हैं और कोरोनावायरस जैसे वायु जनित रोगजनकों के प्रसार को कम कर सकते हैं।''
